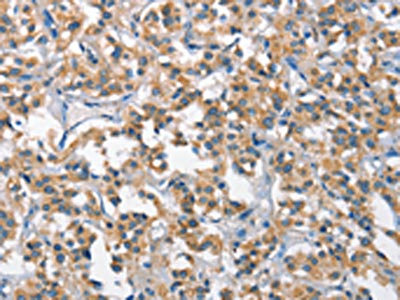

SCARB1 Antibody
-
中文名稱:SCARB1兔多克隆抗體
-
貨號:CSB-PA886284
-
規格:¥1100
-
圖片:
-
The image on the left is immunohistochemistry of paraffin-embedded Human thyroid cancer tissue using CSB-PA886284(SCARB1 Antibody) at dilution 1/65, on the right is treated with fusion protein. (Original magnification: ×200)
-
The image on the left is immunohistochemistry of paraffin-embedded Human gastric cancer tissue using CSB-PA886284(SCARB1 Antibody) at dilution 1/65, on the right is treated with fusion protein. (Original magnification: ×200)
-
-
其他:
產品詳情
-
Uniprot No.:
-
基因名:
-
別名:CD36 and LIMPII analogous 1 antibody; CD36 antibody; CD36 Antigen like 1 antibody; CD36 antigen-like 1 antibody; CD36L1 antibody; CLA 1 antibody; CLA-1 antibody; CLA1 antibody; Collagen type I receptor antibody; HDLQTL6 antibody; MGC138242 antibody; SCARB1 antibody; Scavebger Receptor Class B Member 1 antibody; Scavenger receptor class B member 1 antibody; Scavenger Receptor Class B Type 1 antibody; SCRB1_HUMAN antibody; SR BI antibody; SR-BI antibody; SRB1 antibody; SRBI antibody; Thrombospondin receptor like 1 antibody; thrombospondin receptor-like 1 antibody
-
宿主:Rabbit
-
反應種屬:Human
-
免疫原:Fusion protein of Human SCARB1
-
免疫原種屬:Homo sapiens (Human)
-
標記方式:Non-conjugated
-
抗體亞型:IgG
-
純化方式:Antigen affinity purification
-
濃度:It differs from different batches. Please contact us to confirm it.
-
保存緩沖液:-20°C, pH7.4 PBS, 0.05% NaN3, 40% Glycerol
-
產品提供形式:Liquid
-
應用范圍:ELISA,IHC
-
推薦稀釋比:
Application Recommended Dilution ELISA 1:2000-1:5000 IHC 1:50-1:200 -
Protocols:
-
儲存條件:Upon receipt, store at -20°C or -80°C. Avoid repeated freeze.
-
貨期:Basically, we can dispatch the products out in 1-3 working days after receiving your orders. Delivery time maybe differs from different purchasing way or location, please kindly consult your local distributors for specific delivery time.
-
用途:For Research Use Only. Not for use in diagnostic or therapeutic procedures.
相關產品
靶點詳情
-
功能:Receptor for different ligands such as phospholipids, cholesterol ester, lipoproteins, phosphatidylserine and apoptotic cells. Receptor for HDL, mediating selective uptake of cholesteryl ether and HDL-dependent cholesterol efflux. Also facilitates the flux of free and esterified cholesterol between the cell surface and apoB-containing lipoproteins and modified lipoproteins, although less efficiently than HDL. May be involved in the phagocytosis of apoptotic cells, via its phosphatidylserine binding activity.; (Microbial infection) Acts as a receptor for hepatitis C virus in hepatocytes and appears to facilitate its cell entry. Binding between SCARB1 and the hepatitis C virus glycoprotein E2 is independent of the genotype of the viral isolate.; (Microbial infection) Mediates uptake of M.fortuitum, E.coli and S.aureus.; (Microbial infection) Facilitates the entry of human coronavirus SARS-CoV-2 by acting as an entry cofactor through HDL binding.
-
基因功能參考文獻:
- The data obtained showed that not only cigarette, but also the other environmental stressors reduced SR-B1 expression in epidermal cutaneous tissues and that this effect might be involved in impaired wound healing. PMID: 29102450
- Findings suggested that polymorphism rs5888 had negative association with coronary heart disease, especially in male. [review] PMID: 30103009
- We demonstrate that 4F and Cl/NO2-HDL act on scavenger receptor type I (SR-B1) using human aorta endothelial cells (HAEC) and SR-B1 ((-/-)) mouse aortic endothelial cells. PMID: 29277016
- Our results demonstrate that SR-BI functions as an oncogene and promotes progression of clear cell renal cell carcinoma (ccRCC). SR-BI may serve as a potential prognostic biomarker and therapeutic target for ccRCC. PMID: 29357836
- SCARB1 gene polymorphisms may serve as a potential predictor of treatment responses in chronic hepatitis C patients receiving interferon-based therapy PMID: 27561198
- The S112F single amino acid mutation in SR-BI inhibited the infectivity of hepatitis C virus derived from cell culture in a cell culture model by downregulating the expression of the SR-BI protein. PMID: 28811710
- The cell surface receptor SR-BI (scavenger receptor class B member 1), is essential for hepatitis C virus (HCV) entry into hepatocytes. Variations in the gene coding this receptor influence infectivity and viral load. We analyzed these variations to gain a better understanding of inter-individual differences over the course of HCV infection. PMID: 28363797
- The SCARB1AA genotype decreased cardiovascular risk and carrying GA genotype and G allele increased the risk of CAD. AA genotype carriers had higher levels of big-sized HDL subfraction. PMID: 28882953
- These findings provide new insights into the role of SR-B1 in cellular cholesterol homeostasis and suggest molecular links between SR-B1-dependent lipid sensing and cell cholesterol and lipid droplet dynamics PMID: 29196159
- Liposomes modified with both apolipoproteins A-I and E were internalized in HepG2 cells in FBS-depleted culture medium at the same levels as unmodified liposomes in FBS-containing culture medium, which indicates that apolipoproteins A-I and E were the major serum components involved in liposomal binding to SR-B1 or LDLR (or both). PMID: 28888368
- Here we show that inhibition of SR-B1 reduced cell survival, migration and invasion, and cholesterol content in NB cell lines. Additionally analysis of SR-B1 levels in NB patient biopsies using the R2: Genomics Analysis and Visualization Platform showed that high SR-B1 expression correlated with decreased overall and event-free survival. PMID: 29128352
- the cigarette smoke (CS)-induced loss of SRB1 induced an alteration of sebocytes lipid content, also demonstrated by cholesterol quantification in SRB1 siRNA experiments. In conclusion, exposure to CS, induced SRB1 post-translational modifications in sebocytes and this might affect sebocytes/skin functionality PMID: 27865981
- Our analyses revealed no apparent differences in protein expression profiles of SRBs in central and peripheral regions of human donor tissues, indicating that carotenoid-binding proteins rather than transporters are likely to mediate selective accumulation of carotenoids into the macula. PMID: 28947101
- Low SRB1 expression is associated with non-alcoholic steatohepatitis but is unchanged in hepatocellular carcinoma. PMID: 28941732
- SCARB1 rs5888 and environmental oxidative stress have a prominent role in age-related macular degeneration(ARMD) susceptibility, early ARMD progression to advanced stage disease and even in the outcome of the disease-an area of macular lesion. PMID: 27428740
- SCARB1 gene variants are associated with a new lipid phenotype, characterized by high levels of both HDL cholesterol and Lp(a). SCARB1 exonic variants often result in diminished function of translated SR-B1 via reduced binding/intracellular transport of Lp(a). PMID: 27651445
- Data suggest that activation of SR-BI by APOAI down-regulates sphingosine 1-phosphate/S1PR2-mediated inflammation in vascular endothelial cells by activating the PI3K/Akt signaling pathway; oxidized-LDL does the opposite. (APOA1 = apolipoprotein A-I; SR-BI/SCARB1 = scavenger receptor class B type I; S1PR2 = sphingosine 1-phosphate receptor 2; PI3K = phosphatidylinositol 3-kinase; Akt = proto-oncogene c-akt) PMID: 28181168
- Sustained virologic response was significantly associated with SCARB1 rs10846744 in chronic hepatitis C patients, treated with pegylated interferon-alpha and ribavirin. PMID: 28827115
- Model recombinant HDL (rHDL) particles formed in vitro with S1P incorporated into the particle initiated the internalization of S1PR1, whereas rHDL without supplemented S1P did not, suggesting that S1P transported in HDL can selectively activate S1PR1. PMID: 27881715
- Data implicate that scavenger receptor class B member 1 (SR-B1) as a target in chronic lymphocytic leukemia (CLL) and high-density lipoproteins nanoparticles (HDL NPs) as targeted monotherapy for CLL. PMID: 28061439
- SCARB1 gene polymorphisms may contribute to genetic susceptibility to coronary heart disease. C allele of rs10846744 and the C allele of rs2278986 may serve as risk and protective factors for CHD, respectively. PMID: 28552715
- VEGF-A was found to be a prerequisite for the localization of scavenger receptor BI in the plasma membrane of endothelial cells and is a regulatory factor of transendothelial transport of HDL but not LDL. PMID: 28360088
- our findings implied that scavenger receptor class B type 1 might serve as a diagnostic and independent prognostic biomarker in clear cell renal cell carcinoma. PMID: 28466781
- data support an SR-B1 nibbling mechanism that is similar to that of streptococcal serum opacity factor, which also selectively removes CE and releases apoAI, leaving an apoAII-rich remnant. PMID: 28373285
- Using mass spectrometry and site directed mutagenesis, a new Sp1 phosphorylation site Ser702 was defined to be associated with Sp1-HDAC1 interaction and may be important in SR-BI activation, shedding light on the knowledge of delicate mechanism of hepatic HDL receptor SR-BI gene modulation by LDL. PMID: 27320013
- down-regulation of SR-BI by endoplasmic reticulum stress in hepatic cells might contribute to the unfavorable effects of metabolic disorders on cholesterol homeostasis and cardiovascular diseases PMID: 27666478
- We confirmed associations with papillary thyroid cancer and SNPs in FOXE1/HEMGN, SERPINA5 (rs2069974), FTO (rs8047395), EVPL (rs2071194), TICAM1 (rs8120) and SCARB1 (rs11057820) genes. We found associations with SNPs in FOXE1, SERPINA5, FTO, TICAM1 and HSPA6 and and follicular thyroid cancer PMID: 27207655
- We engineered a library of infectious HCV with all codons represented at most positions in the ectodomain of the E2 gene. Nine variants showed reduced dependence on scavenger receptor class B type I (SR-BI) for infection. PMID: 27630236
- The data from this ex vivo study suggests that up-regulated SR-B1 protein expression is associated with malignant behaviors of breast cancer and that SR-B1 is an independent predictor for poor survival in breast cancer patients. PMID: 27067809
- ApoA-I induces S1P release from endothelial cells through ABCA1 and SR-BI in a positive feedback manner. PMID: 27377933
- As proof-of-concept, human serum exosomes were found to express SR-B1, and HDL NPs can be used to label and isolate them. PMID: 26964503
- Shear stress regulates endothelial cell function through SR-B1-eNOS signaling pathway. PMID: 27225585
- Data indicate that high scavenger receptor class B type I (SR-BI) expression was an independent unfavorable prognostic factor for overall survival (OS), and that high SR-BI expression could be used as a potential prognostic marker in breast cancer patients. PMID: 26456958
- CLA1 transport activity is necessary for the acquisition of host phosphatidylcholine by C. trachomatis. PMID: 26381674
- the single nucleotide polymorphism (rs5888) within SCARB1 is independently associated with premature coronary artery disease in a sex-dependent manner. PMID: 26754576
- SR-B1 and targeted HDL NPs provide a fundamental advance in studying cholesterol-dependent cellular uptake mechanisms. PMID: 26511855
- contributes to LDL transcytosis PMID: 26334034
- PGG enhances expression of SR-BI and ABCA1 in J774 and THP-1 macrophages PMID: 26322417
- hSR-BII, and to a lesser extent hSR-BI, significantly increase LPS-induced inflammation and contribute to LPS-induced tissue injury in the liver and kidney, two major organs susceptible to LPS toxicity. PMID: 26936883
- Intestinal activation of LXR reduces the production of chylomicrons by a mechanism dependent on the apical localization of SR-B1. PMID: 26602218
- resistance to HCV in HIV+ patients may be related to genetic variation in SCARB1 or OCLN PMID: 26571379
- Nrf2 activation and the expression and oxidative posttranslational modification of SRB1 are impacted in CDKL5 related Rett syndrome. PMID: 26006105
- These results suggest that EPA inhibits intestinal beta-carotene absorption by down regulation of SR B1 expression via PPARalpha dependent mechanism and provide an evidence for dietary modulation of intestinal beta-carotene absorption. PMID: 26577021
- Data show consistent association of scavenger receptor class B member 1 (SCARB1) variants with high-density lipoprotein cholesterol (HDL-C) across various association analyses, suggesting the role of SCARB1 in lipoprotein-lipid regulatory mechanism. PMID: 26563154
- SCARB1 P376L is associated specifically with elevated HDL cholesterol level and risk of coronary heart disease. PMID: 26965621
- Propofol up-regulates expression of ABCA1, ABCG1, and SR-B1 through the PPARgamma/LXRalpha pathway in THP-1 macrophage-derived foam cells. PMID: 25600616
- SCARB1 missense rs4238001 is statistically significantly associated with incident CHD. PMID: 25993026
- Hepatic SR-BI is associated with type 2 diabetes but unrelated to human and murine non-alcoholic fatty liver disease. PMID: 26431876
- These observations confirm the role of CD81 in liver-stage malaria and question that of scavenger receptor class B member 1. PMID: 25656410
- Variants of SCARB1 and VDR Involved in Complex Genetic Interactions May Be Implicated in the Genetic Susceptibility to Clear Cell Renal Cell Carcinoma. PMID: 25945350
顯示更多
收起更多
-
亞細胞定位:Cell membrane; Multi-pass membrane protein. Membrane, caveola; Multi-pass membrane protein. Note=Predominantly localized to cholesterol and sphingomyelin-enriched domains within the plasma membrane, called caveolae.
-
蛋白家族:CD36 family
-
組織特異性:Widely expressed.
-
數據庫鏈接:
Most popular with customers
-
-
YWHAB Recombinant Monoclonal Antibody
Applications: ELISA, WB, IHC, IF, FC
Species Reactivity: Human, Mouse, Rat
-
Phospho-YAP1 (S127) Recombinant Monoclonal Antibody
Applications: ELISA, WB, IHC
Species Reactivity: Human
-
-
-
-
-